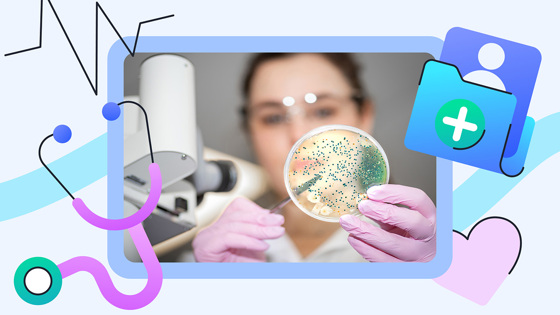

Как микробиом влияет на здоровье: 12 важных вопросов
Вы наверняка слышали, что в организме человека около двух килограммов бактерий. По последним данным, вес микробиома — всего 200 граммов. При этом он играет огромную роль в состоянии здоровья. Разобрались в деталях.
О чём речь?
Бактерии, вирусы и грибки обитают на коже, в кишечнике, во рту, в лёгких и даже в глазах. Вместе они образуют микробиом. Это сложная экосистема, без которой организм не смог бы функционировать.
У каждого человека микробиом уникален, как отпечатки пальцев. Состав этой коллекции зависит от многих факторов.
Это образ жизни, питание и даже то, как вы появились на свет: через естественные роды или кесарево сечение.
И много их?
Ещё лет 20 назад считалось, что микробов в организме человека в несколько раз больше, чем собственных клеток. Предполагалось, что весь микробиом весит около двух килограммов.
Недавние исследования это опровергли. Человек массой 70 кг в среднем состоит из 30 триллионов клеток. А микробов у него — около 39 триллионов. По весу это как пачка масла — около 200 граммов.
А для чего они нам нужны?
Микробиом выполняет массу важных функций. Кишечные бактерии помогают переваривать пищу, в частности клетчатку, синтезируют витамины и другие полезные вещества. Микрофлора защищает от вредных бактерий. Последние не могут размножаться, поскольку всё пространство уже занято.
Это ещё не всё. Исследования показывают, что микробиом влияет на настроение и даже на поведение.
Учёные уже нашли связь между состоянием кишечной флоры, тревожностью и депрессией.
Кишечные бактерии и депрессия? Как такое может быть?
Учёные называют это «ось кишечник — мозг». Бактерии принимают участие в синтезе нейромедиаторов. Это химические вещества, которые передают сигналы от одной нервной клетки к другой. Например, до 90% серотонина, который отвечает за счастье, вырабатывается не в мозге, а в кишечнике.
Микробиом также влияет на работу блуждающего нерва — связующего звена между кишечником и мозгом. Установлено, что импульсы по блуждающему нерву идут не только сверху вниз (от мозга в брюшную полость), но и обратно.
А как так получается, что микробиом начинает вредить?
Микробиом состоит из тысяч разных бактерий. Их условно можно разделить на хорошие и плохие. Последних должно быть мало. Бывает так, что плохие начинают активно размножаться, из-за чего нарушается баланс. Такое состояние называют дисбактериозом. В кишечнике начинают доминировать микробы, выделяющие вредные вещества. Это приводит к нарушению пищеварения, ожирению, воспалениям и многим другим проблемам со здоровьем.
Не совсем болезнь: что такое дисбактериоз и почему сложно от него избавиться

Что может нарушить баланс микрофлоры?
Больше всего вредят:
- антибиотики — убивают не только патогенные, но и полезные бактерии;
- нездоровое питание — обилие сахара и недостаток клетчатки в рационе (полезные бактерии лишаются пищи);
- стресс — повышает уровень гормона кортизола, который отрицательно сказывается на состоянии микрофлоры,
- нехватка сна — нарушает циркадные ритмы, а также работу органов, в том числе и кишечника (вместе с микробиомом);
- когда слишком чисто, разнообразие бактерий становится меньше.
Можно ли вернуть микробиом в норму?
Да, можно. Для этого нужно:
- есть больше овощей, фруктов и бобовых (источники клетчатки);
- высыпаться;
- ограничить потребление сахара и ультрапереработанной пищи;
- быть физически активным — минимум 150 минут умеренных физических нагрузок в неделю.
Хорошие и плохие углеводы: что нужно о них знать
А если выпить полезные бактерии, например йогурт?
Йогурт и кефир — источники полезных кисломолочных бактерий. Их ещё называют пробиотиками. Теоретически они должны помогать, но на практике всё не так однозначно. Пока непонятно, чего в пробиотиках больше — науки или маркетинга.
Гораздо надёжнее кормить свои собственные бактерии. Для этого нужны пребиотики (не путать с пробиотиками). Это вещества, которыми питаются полезные микробы.
Пребиотики — это клетчатка и некоторые сложные углеводы, которые не перевариваются в желудке, но доходят до кишечника. Там они становятся едой для хороших бактерий.

Как понять, что микрофлора нарушена? Проводят ли какие-то анализы?
Явных симптомов нет. Однако по некоторым косвенным признакам это можно заподозрить. Среди таких проявлений:
- нарушение пищеварения — частое вздутие, запоры, диарея,
- кожные высыпания,
- частые простуды,
- повышенная утомляемость,
- перепады настроения, тревожность.
Оценить состав микробиома можно с помощью секвенирования — анализа геномов бактерий взятого образца. Такой тест очень дорогой, и пока не до конца понятно, как его интерпретировать.
Дело в том, что микробиом уникален — у каждого он свой и зависит от очень многих факторов. Поэтому каким он должен быть в идеале, неизвестно.
То есть пока науке известно только о некоторых видах нарушения микрофлоры?
Да. Например, установлено, что у людей с ожирением чаще всего в кишечнике превалируют бактерии-фирмикуты (Firmicutes). Они лучше расщепляют сложные углеводы и помогают извлекать из еды больше калорий. А вот у стройных людей доминируют бактерии типа Bacteroidetes. Они мешают усваиваться калориям и способствуют снижению уровня сахара. Сегодня уже практикуют методы лечения ожирения путём трансплантации фекальной микробиоты.
Что значит пересадка кала?
Сегодня эту методику активно изучают. В частности, это касается лечения некоторых инфекций и ожирения. Практикуют пересадку кишечной микробиоты от одного или нескольких здоровых доноров пациенту. Микробиоту вводят либо через толстую кишку, либо с помощью зонда — через пищевод в двенадцатиперстную кишку.
Целесообразность такого лечения пока под вопросом. Одни исследования показывают его эффективность, а другие её опровергают.
Главное: микробиом — друг или враг?
Однозначно друг. Но многое зависит от того, как вы к нему относитесь, чем вы его кормите. Если это сладости и фастфуд, то вы взрастите врага.
Помните, что человек появился гораздо позже бактерий и наше сожительство — плод эволюции. Микробиом — такая же неотъемлемая часть нас, как сердце, желудок или мозг. Как лечить микробиом, науке известно не до конца.
Важные исследования:
Переоценка количества клеток человека и бактерий в организме — о том, что число бактерий в теле человека примерно равно количеству его собственных клеток, опровергнуто широко распространённое соотношение 10:1.
Клетчатка и пребиотики: механизмы и польза для здоровья — о пользе пищевых волокон для здоровья.
Микробиота кишечника при тревоге и депрессии: систематический обзор — о том, как изменения в составе кишечного микробиома связаны с тревожными и депрессивными расстройствами.
Влияние трансплантации фекальной микробиоты на ожирение и метаболический синдром — о том, как пересадка кишечной микробиоты улучшает чувствительность к инсулину, но не оказывает значительного влияния на массу тела и уровень глюкозы натощак.